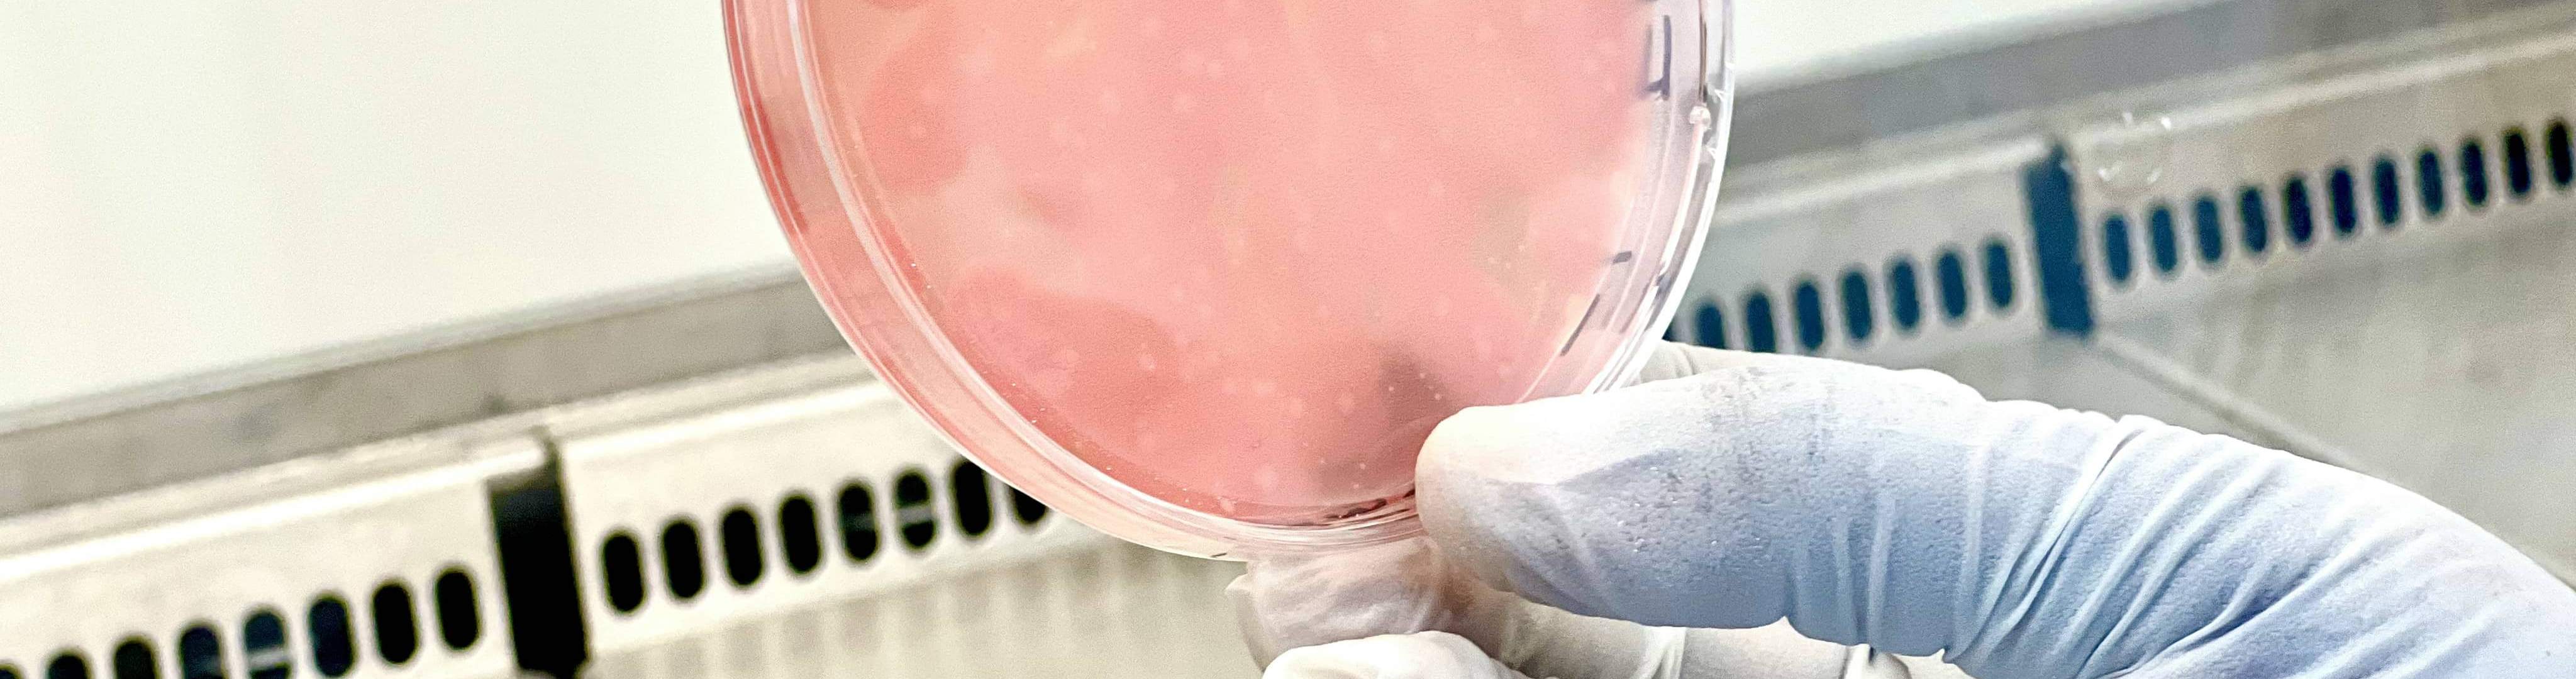
Microbiologie Aliments

Microbiology Food
- Sampling - analysis - rendering of test reports
The LSAHE provided you with ISO reference methods for your expertise and AFNOR validated rapid methods for the microbiological monitoring of your food products.
Available settings
Aerobic total mesophiles *; Sulfite-reducing anaerobes *; Bacillus cereus *; Campylobacter spp; Coliforms *; Thermotolerant coliforms *; Clostridium perfringens; Enterobacteriaceae *; Escherichia coli *; Escherichia coli O 157 H7; Yeasts and molds *; Listeria monocytogenes *; Pseudomonas aeruginosa; Salmonella spp *; Shigella spp; Staphylococcus aureus *, Vibrio cholerae, Vibrio alginolyticus; Vibrio parahaemolyticus; Vibrio spp; lactic flora; Yersinia (* = accredited parameter)
Available food profile
- Meats and derivatives
- Fishery products
- Live shells
- Dietetic foods
- Semi-preserves
- Composed dishes
- Additives